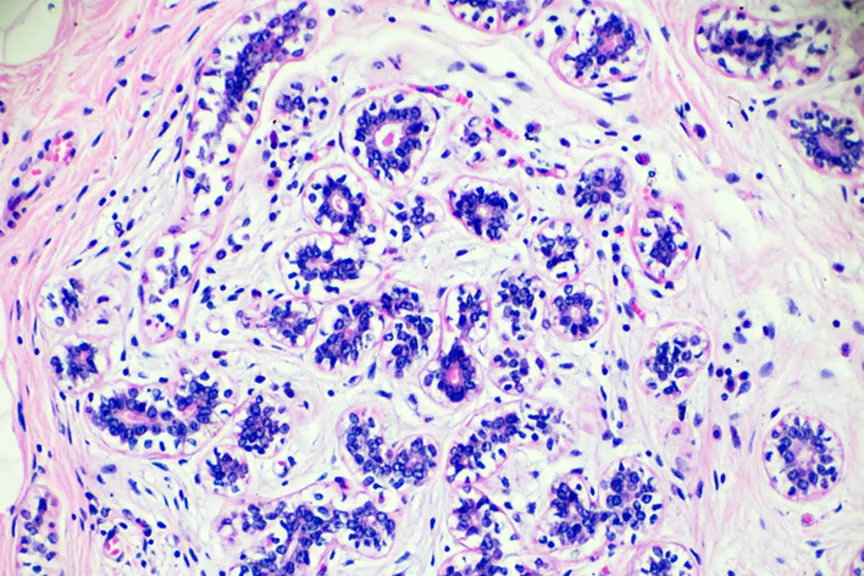

乳腺癌患者何时应选择化疗?
一项新的基因检测可能有一天会帮助女性和她们的医生做出更自信的决定。
化疗、激素治疗,当你被诊断出患有乳腺癌时,所有的治疗方案都可能让你望而生畏。但一项新的基因测试可能很快就会让化疗的决定变得容易得多。
来自伦敦玛丽女王大学的研究人员使用多基因检测endpredict来评估化疗是否对患有最常见的癌症的女性有益乳腺癌(雌激素受体阳性,her2阴性),根据发表在乳腺癌研究与治疗。一般来说,医生建议化疗的妇女有很高的风险转移(当癌症扩散)。
研究人员与维也纳的奥地利乳房和结肠直肠组织(Austrian Breast and Colorectal Group)和马德里的西班牙乳腺癌基金会研究小组(Spanish Foundation Research Group in Breast Cancer)的科学家一起,对近4000名女性进行了三项大型临床试验。结果令人印象深刻:经endpredict鉴定为高危的女性,在10年的时间里接受了除激素治疗外的化疗,比未接受激素治疗的女性在统计学上有更好的结果。
这项测试的一个关键好处是它可以帮助女性避免化疗带来的心理和生理上的严重损失。“我们的数据显示,如果结果显示女性的复发风险较低,那么使用end预测测试来评估转移的风险可以避免女性进行不必要的化疗,”该研究的主要作者、玛丽女王大学的Ivana Sestak博士在一份报告中说新闻稿。
并不是每个乳腺癌患者都被推荐化疗,但有时很难判断化疗是否有用。一般来说,医生会对患者进行基因测试,并观察肿瘤大小和分级等,以确定雌激素受体阳性乳腺癌患者的最佳治疗方案。85%的女性乳腺癌患者受雌激素受体阳性影响。
研究人员说,在判断预后和治疗的典型方法不充分的情况下,这种新的测试可以帮助提供答案。在这种测试公开之前还需要更多的研究,但基于这些研究结果,它可能有一天会成为一种重要的治疗工具。的OncoType DX化验该测试是对病人已经可用的测试的补充。新的基因检测对决定激素治疗、放疗或手术没有帮助。其他预后多基因分析可能被认为有助于评估复发风险,但尚未被证实可以预测化疗反应。